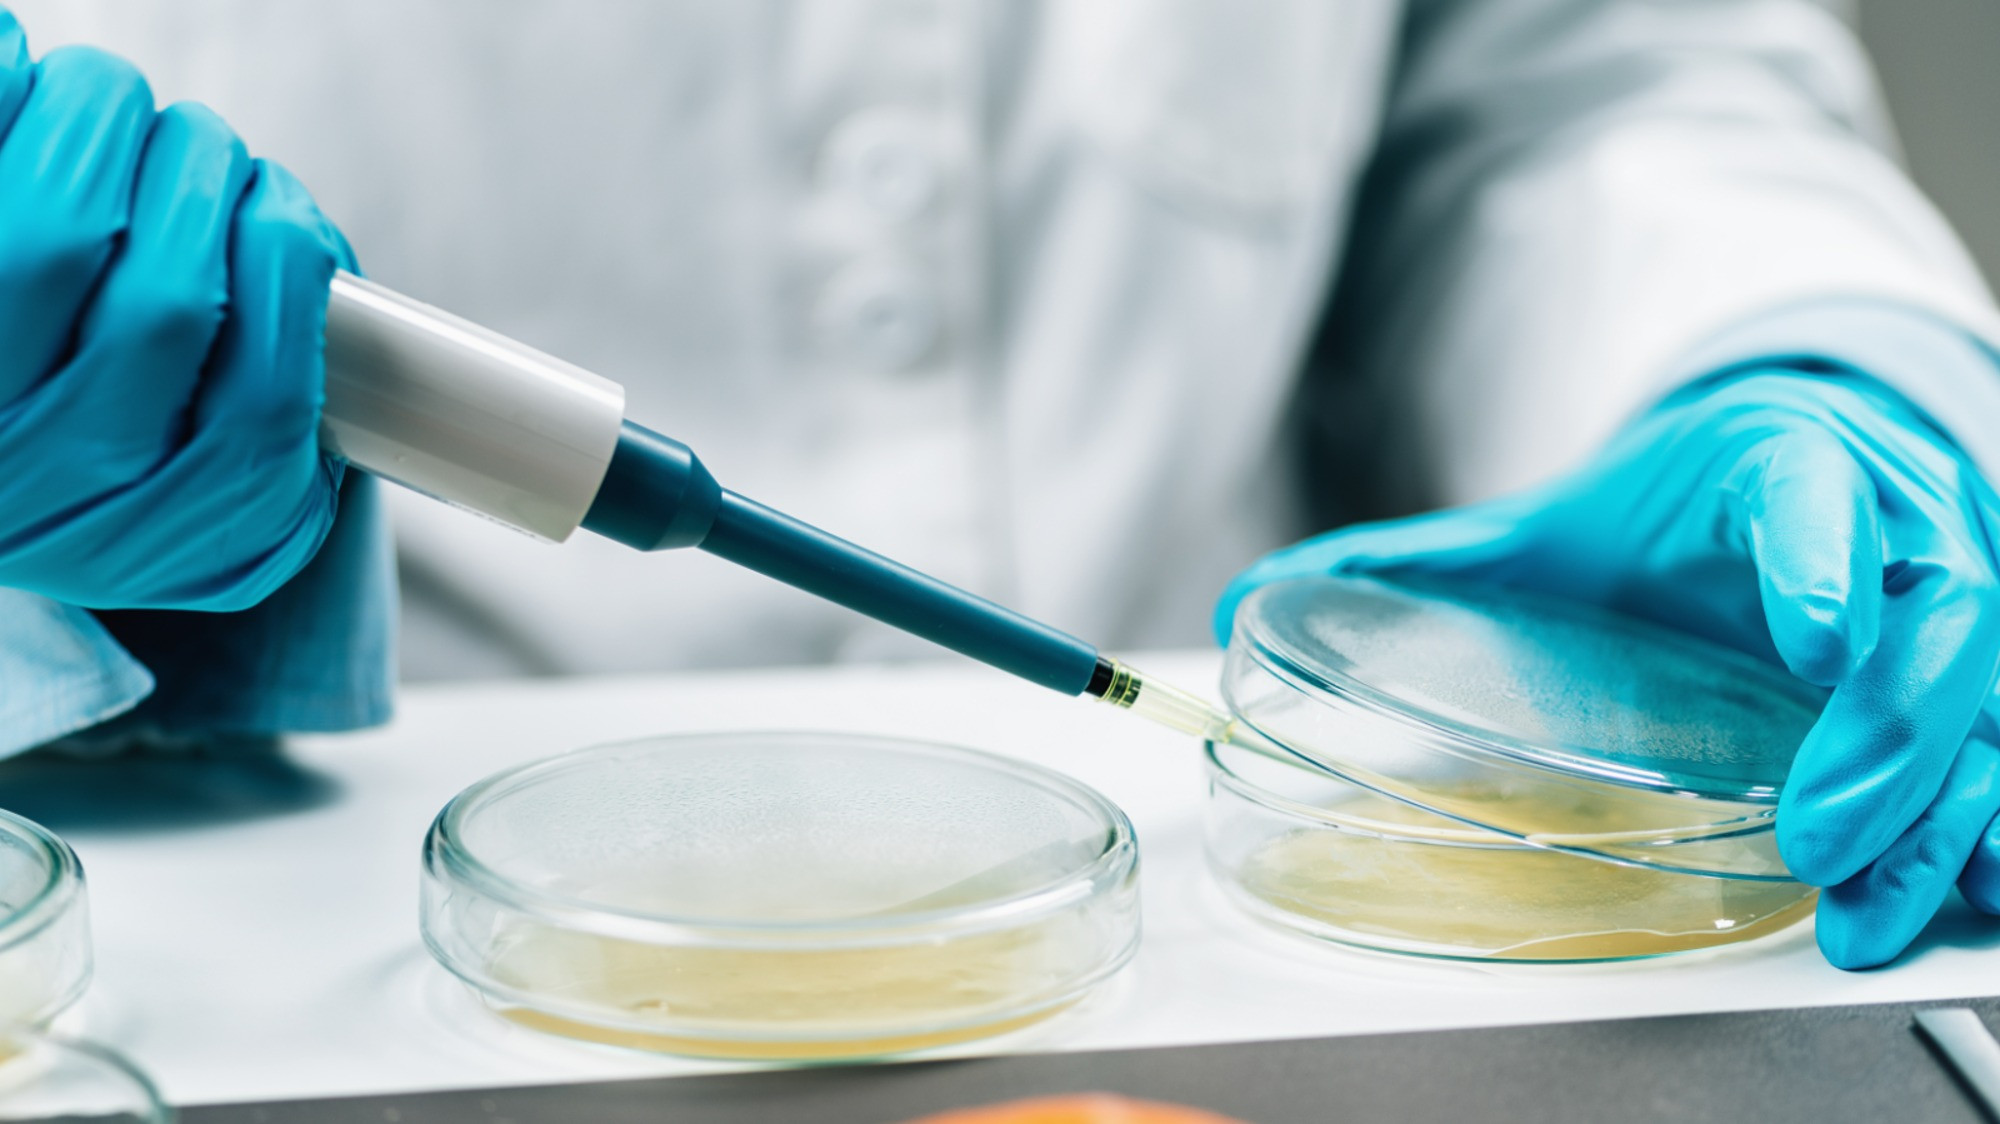

Food sampling
Зиппо хотелось
Земли составляющие территорию муниципального образования
Когда выходят новые iphone
Как покрасить арку из баллончика
Как подключить беспроводной модем
Уголовный кодекс статья 228 ч 2
Азитромицин 50
Доброе утро картинки анимация красивая гифка
Доброе утро прикольное пожелание с юмором мужчине
Biz 1c
Fx37 2012 подрамник передний бу екатеринбург
Люберцы авиаторов 2 корп 2
История 6 класс стр 39 номер 5
Food sampling 113 фотографий